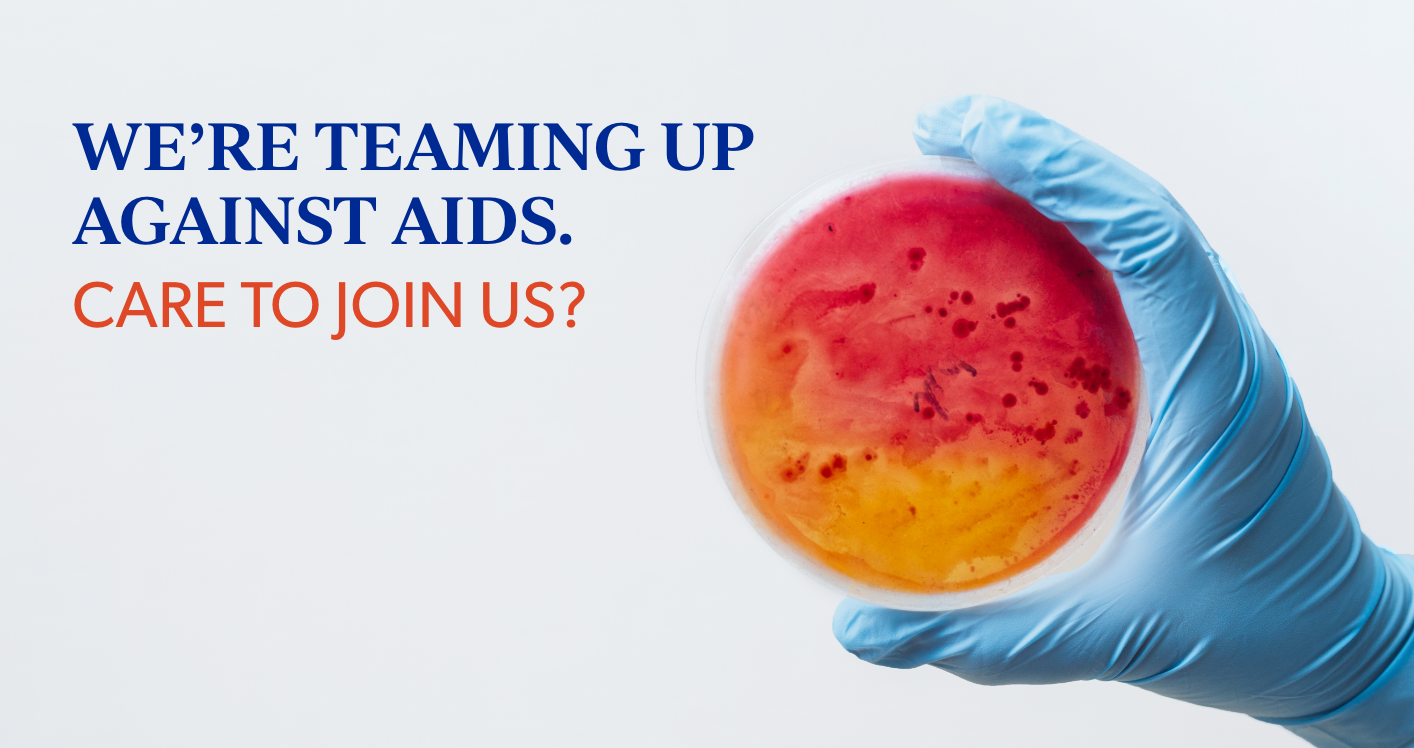

amfAR
Art Direction, Brand Expansion, Brand Identity, Brand Messaging, Design Direction, Information Design, Publication Design, Social Media, Web Design
Creative Direction: Clarke
amfAR, The Foundation for AIDS Research, is one of the world’s leading nonprofit organizations dedicated to the support of AIDS research, HIV prevention, treatment education, and advocacy. For years, amfAR’s work has been split between bold scientific research and flashy fundraising galas. We were approached for a brand refresh that unifies the two sides of the organization.

Through bold colors, energetic typography, and striking imagery, we were able to craft a brand that celebrates the livelier side of amfAR without sacrificing scientific integrity or clarity. The updated brand was executed across a number of materials including the website, brochures, infographics, reports, and brand handbook.